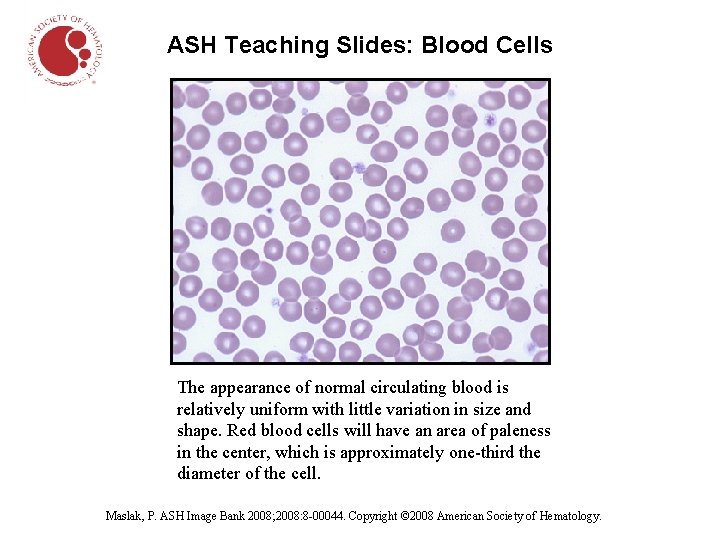
ASH Teaching Slides: Blood Cells The appearance of normal circulating blood is relatively uniform

ASH Teaching Slides Blood Cells The appearance of
ASH Teaching Slides: Blood Cells The appearance of normal circulating blood is relatively uniform with little variation in size and shape. Red blood cells will have an area of paleness in the center, which is approximately one-third the diameter of the cell. Maslak, P. ASH Image Bank 2008; 2008: 8 -00044. Copyright © 2008 American Society of Hematology.

ASH Teaching Slides: Blood Cells Normal blood smear. The four larger cells shown are called granulocytes, a type of white blood cell. Maslak, P. ASH Image Bank 2008; 2008: 8 -00067. Copyright © 2008 American Society of Hematology.

ASH Teaching Slides: Blood Cells Iron-deficiency anemia is indicated by red blood cells that are paler and of a smaller size than normal. Schrier, S. ASH Image Bank 202; 2002: 100345. Copyright © 2002 American Society of Hematology.

ASH Teaching Slides: Blood Cells Blood smear; arrows indicate sickled cells. Schrier, S. ASH Image Bank 2001; 2001: 100248. Copyright © 2001 American Society of Hematology.

ASH Teaching Slides: Blood Cells Chronic myelogenous leukemia. The blood smear shows an increased number of neutrophils, a type of white blood cell. Maslak, P. ASH Image Bank 2001; 2001: 100202. Copyright © 2001 American Society of Hematology.

ASH Teaching Slides: Blood Cells Hairy cell leukemia. The characteristic cell of this type of leukemia has projections uniformly distributed around its border that give it a hairy appearance. Maslak, P. ASH Image Bank 2007; 2007: 7 -00011. Copyright © 2007 American Society of Hematology.

ASH Teaching Slides: Blood Cells Hodgkin lymphoma. The large cells with an owl-like appearance are called Reed-Sternberg cells and are a sign of Hodgkin lymphoma. Kadin, M. ASH Image Bank 2002; 2002: 100484. Copyright © 2002 American Society of Hematology.
- Slides: 7